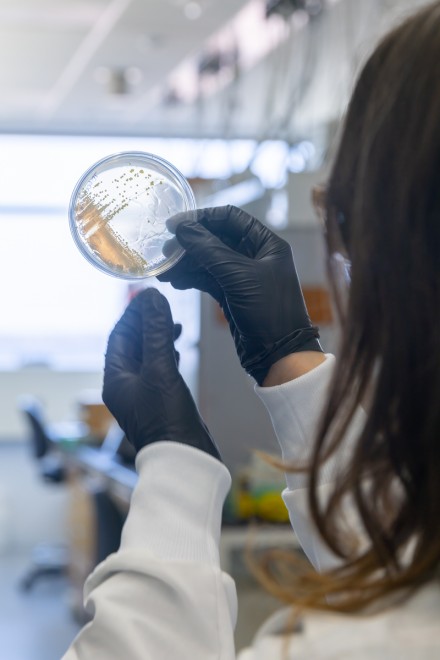

In this series, we learn more about what inspired our talented graduate students and postdoctoral researchers, what brought them to their field of study, and the questions that drive their work at the Great Lakes Bioenergy Research Center (GLBRC). Responses are edited for clarity and length.
Samatha Kelly is a first year PhD student in the Donohue and Noguera labs. She works in late-stage bioprocessing, engineering microbes to break down complex plant structures like lignin and to separate the most useful products.
How did you get into this research?
I've always been interested in the sphere of renewable energy. I had my first research experience after I finished my undergrad. I did a couple internships, and specifically some internships with the Department of Energy, where I was working on different stages of biomass conversion into biofuels, and that really interested me. I also worked in a lab where I did some research on electrochemical separations and mechanisms that interested me. When I was looking for grad school, the Donahue and Noguera labs kind of had a little bit of everything. I could work on separation and creating bioproducts.
What excites you about working with the GLBRC?
Sometimes when you're in a lab, just in a university, you have less opportunities for connections with people outside. Before I came here, I worked at a national lab, so I was also working with the DOE, and I really liked the idea of working with the government agency, because my career goal is to work with a government agency, ideally on the science policy sphere. I felt like it would be a good place to gain connections.
What’s your dissertation topic?
Our lab is part microbiologists and geneticists, and then it's part engineers. For example, my advisor, Dan Noguera, he's the engineer, and then Tim Donohue, the other advisor, he's the microbiologist/bacteriologist/geneticist. It's very collaborative.
You said you're interested in working in policy. What part are you drawn to?
I'm still trying to figure it out, but I'm interested in informing sustainability policy. Some hot topics that I really care about are climate change, for example. maybe working in a project management position where I could facilitate resources towards those initiatives Or working more in the science communication sphere. basically something like a liaison communicating science from the lab to the policy makers.
Why didn’t you do any research as an undergraduate?
I was just so busy with classes. I went to the University of Denver, and I got a double major in math and environmental science, and I got a minor in music. Engineering was something I never thought I'd get into. It kind of happened by chance, but I had that science background and I was interested in research. I was a tour guide. I would tell everybody, you could do research at this school, and it's so cool. I just didn't have the time to do it. When I graduated, I was super burnt out. I didn't know what I wanted to do. So I applied to one internship with NASA Earth Sciences, and I got rejected. I guess somebody dropped out, and then I got into it. So I was like, okay, NASA. I can't pass that up. It was all remote sensing computer work, analyzing satellite data, basically. Okay, I like the idea of research, but I don't like this research. So let me try to do another internship where I could have some hands-on experience. So I went from New York to Argonne National Lab. And I was like, I really like this. Let me do another one with a different group. I found a lab, and they hired me as a research aide for a year. I was like, I think I want to do research, so I might as well just pivot to the PhD.
If you were going to give any advice to your undergraduate self, what would you tell her?
I first got introduced to science and research when I was pretty young. I went to a lot of science outreach events and then I did a lot of stuff with my school. It was always so interesting to me, but I kind of put it aside because I didn't know that you could combine your different interests. I know it's super stressful to just be focusing on classes all the time, but just to take time to kind of like, zoom out and think of the big picture and think of the stuff that excited you when you were younger, and take as many opportunities as you can. Just don't be afraid to go for it.
You said you did music. Did you play an instrument?
I really love to sing, so I'm in a community choir here that meets on the east side of Madison once a week. When I was in high school I played the flute and the piano but decided to pivot it into more of a hobby so I could still have the love of it. Then when I was in college I also played the bell tower instrument. It's called a carillon.
Wait, wait, wait, like in a big bell tower? Like the one that chimes on the hour?
Well, I didn't play the hour. I played songs.

How do you even get that job?
I guess it was my freshman year college, they had a parent visit weekend. It's got a very famous bell tower,. the woman who plays the bell tower was just like, super nice. And she was like, oh, you want to see the bell tower? feel free to come on down. I just reached out to her, and I was like, Hey, you met me, like, two years ago. Do you want to give me lessons? And she was like, yeah. it goes back to like, just take opportunities. They're everywhere.
What else do you like to do outside of work?
I really like to bake. I mean, getting really into baking sourdough. I have a starter. It doesn't have a name yet, but it’s about two or three months old. I’ve been making sourdough discard bagels every two weeks and I think I’ve finally perfected the recipe.
What previous skills helped you get where you are?
I think that the fact that I took time off in between my bachelor's and my graduate degree, even though it was a little scary. I feel like that was so valuable, and I keep recommending it to everybody. When you're doing these shorter term things, you have a little bit more opportunity to learn one-on-one. I made so many mistakes, so many research mistakes, but it was okay.





